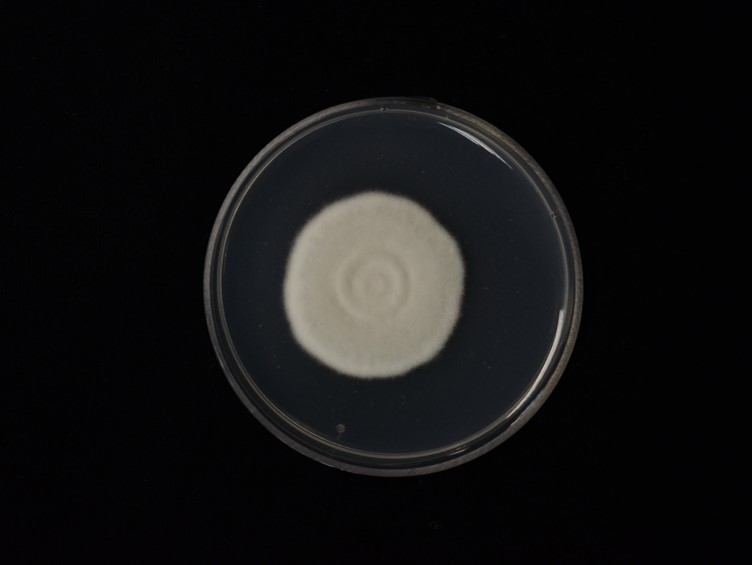

Holotype:
THAILAND, Phitsanulok Province, Ban Phao Thai Community Forest, 10 Oct. 2015, S. Mongkolsamrit, D. Thanakitpipattana, W. Noisripoom, A. Khonsanit, holotype BBH 40672, ex-type living culture BCC 79666.
Habitat:
Buried in the soil.
Host:
Gryllidae.
Description:
 Stroma solitary, cylindrical, arising from the head of cricket nymph buried in the ground, 37-40 × 1-1.5 mm. Fertile part cylindrical to clavate, pale grey, ostiole dark grey, up to 25 mm long, 2-3 mm wide.
Stroma solitary, cylindrical, arising from the head of cricket nymph buried in the ground, 37-40 × 1-1.5 mm. Fertile part cylindrical to clavate, pale grey, ostiole dark grey, up to 25 mm long, 2-3 mm wide.  Perithecia completely immersed, ordinal in arrangement, ovoid to obclavate, 460-580 × 180-300 µm.
Perithecia completely immersed, ordinal in arrangement, ovoid to obclavate, 460-580 × 180-300 µm.  Asci cylindrical with thickened ascus apex, 8-spored, 250-400 × 4-5 μm. Ascus-cap rounded.
Asci cylindrical with thickened ascus apex, 8-spored, 250-400 × 4-5 μm. Ascus-cap rounded.  Ascospores divided into 64 part-spores after maturity, 300-450 × 1 μm, part-spores cylindrical, 4-10 × 1 μm.
Ascospores divided into 64 part-spores after maturity, 300-450 × 1 μm, part-spores cylindrical, 4-10 × 1 μm.
Culture characteristics:
Colony on PDA fast growing, attaining ca 2.2 cm diam after 21 d at 20 °C, white to cream with distinct margin.
Colony on PDA fast growing, attaining ca 2.2 cm diam after 21 d at 20 °C, white to cream with distinct margin.  Phialides flaskshaped with distinct neck, 3–7 × 1.5–2 μm.
Phialides flaskshaped with distinct neck, 3–7 × 1.5–2 μm.  Conidia not in chains, hyaline, 1-celled, fusiform, 3–7 × 2–3 μm.
Conidia not in chains, hyaline, 1-celled, fusiform, 3–7 × 2–3 μm.
Reference:
Thanakitpipattana D, Tasanathai K, Mongkolsamrit S, et al.(2020). Fungal pathogens occurring on Orthopterida in Thailand. Persoonia 44: 140–160.
DOI: https://doi.org/10.3767/persoonia.2020.44.06Species |
Strain |
Compound |
Pubchem CID |
Biological activity |
Reference |
|---|
|
Strain |
|---|